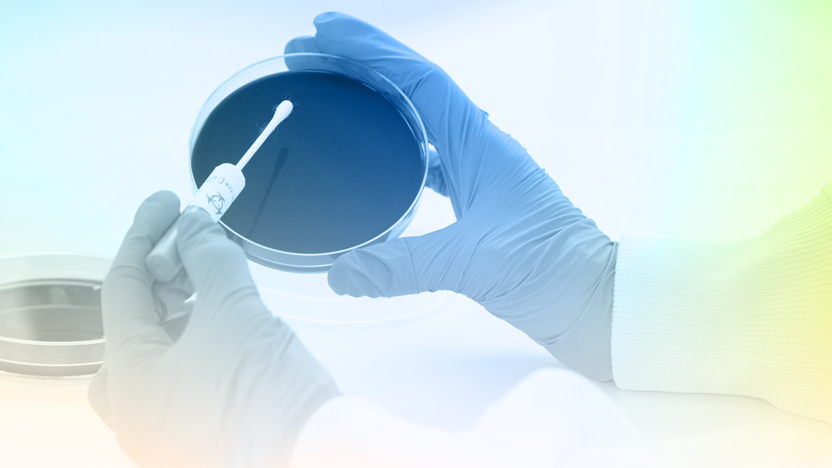
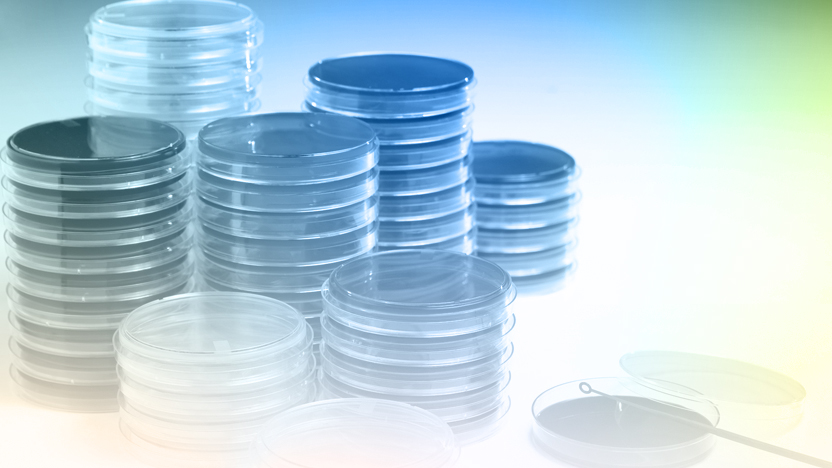

Willkommen bei Doenitz ProLab - Partner der Labore seit über 25 Jahren
Produktauswahl

KWIK-STIK™ 2er Packung
Gebrauchsfertige, qualitative, lyophilisierte Mikroorganismen in Stiftform Max. 3. Passage

EZ-Accu Shot™
Quantifizierter Mikroorganismus mit < 100 CFU pro 0,1 ml Inokulum bis zu 50 Tests pro…

Helix Elite™ Inaktivierter Standard
Chlamydia trachomatis / Neisseria gonorrhoeae (CT/NG), inaktiviert Stamm LGV-2-434 und GL0071
Aktuelles

Neu im Sortiment: Bioindikatoren 🧪
Wir freuen uns, Ihnen mitteilen zu können, dass wir unser Portfolio in Kürze um biologische Indikatoren (BI) zur Überwachung und…
Mehr erfahren 18. Mai 2026

Wir sind auf der LAB-SUPPLY in Hannover dabei!
Treffen Sie uns am 20.05.2026 auf der regionalen Fachmesse für instrumentelle Analytik, Labortechnik, Laborchemikalien und Life Science!
Mehr erfahren 18. Mai 2026

Das Labbox-Sortiment ab sofort bei uns! 🔬
Als Distributor für Labbox haben wir tolle Angebote für Sie. Kontaktieren Sie uns! Gerne senden wir Ihnen einen Printkatalog.
Mehr erfahren 10. Feb. 2026

Legionella enumeration by ISO 11731: Limits and Biases
A new webinar that should be highly relevant to laboratories and stakeholders involved in Legionella field.
Mehr erfahren 20. Jan. 2026

Besuch der Diamidex-Zentrale in Marseille
Kennenlernen des Teams und der Technik von Diamidex
Mehr erfahren 20. Jan. 2026

Von pharmazeutischen Mikrobiologen für pharmazeutische Mikrobiologen
Unser erstes ProLab-Seminar Nord fand am 05.11.2025 in Trittau bei Hamburg statt.
Mehr erfahren 17. Nov. 2025

The Next Step for Bioburden Testing in Water
This session is designed for scientists, microbiologists, and lab managers who want to understand the real innovation behind rapid TVC…
Mehr erfahren 17. Sep. 2025

Accelerate Your E. Coli Testing with 6 Hours Results
E. coli remains a major challenge in water testing — but what if results didn’t take 24 hours anymore?
Mehr erfahren 17. Sep. 2025

How Quick is KWIK-STIK™?
Wie einfach der Einsatz von Referenzmikroorganismen sein kann.
Mehr erfahren 07. Juli 2025

Rückruf-Service
Kontaktieren Sie uns - Wir sind jederzeit für Sie da!